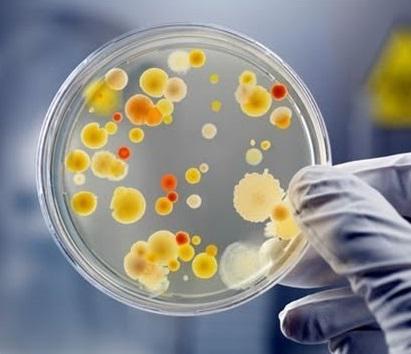

Press release
Microbial Cultures Market 2025 Global Analysis By Key Players - Chr. Hansen, DuPont, DSM, Evonik, HiMedia, Ingredion, Kerry Group, Naturex & More, Etc.
An Exclusive Market Reports “Global Microbial Cultures Market Size Status and Forecast 2025”, The report classifies the global Microbial Cultures Market in a precise manner to offer detailed insights about the aspects responsible for augmenting as well as restraining market.Request Sample Copy Of this Report @ https://www.upmarketresearch.com/home/requested_sample/77531
Microbial Cultures Market research report delivers a close watch on leading competitors with strategic analysis, micro and macro market trend and scenarios, pricing analysis and a holistic overview of the market situations in the forecast period.
It is a professional and a detailed report focusing on primary and secondary drivers, market share, leading segments and geographical analysis. Further, key players, major collaborations, merger & acquisitions along with trending innovation and business policies are reviewed in the report. The report contains basic, secondary and advanced information pertaining to the Microbial Cultures Market global status and trend, market size, share, growth, trends analysis, segment and forecasts from 2018 – 2025.
The scope of the report extends from market scenarios to comparative pricing between major players, cost and profit of the specified market regions. The numerical data is backed up by statistical tools such as SWOT analysis, BCG matrix, SCOT analysis, PESTLE analysis and so on. The statistics are represented in graphical format for a clear understanding on facts and figures.
The generated report is firmly based on primary research, interviews with top executives, news sources and information insiders. Secondary research techniques are implemented for better understanding and clarity for data analysis.
The report for Microbial Cultures Market analysis & forecast 2018- 2025 is segmented into Product Segment, Application Segment & Major players.
Region- wise Analysis Microbial Cultures Market covers:
• North America
• Europe
• China
• Japan
• India
• Southeast Asia
• Other regions (Central & South America, Middle East & Africa)
For More Information On This Report, Please Visit @ https://www.upmarketresearch.com/home/enquiry_before_buying/77531
The Major Players Reported In The Report Are:
• Chr. Hansen
• DuPont
• DSM
• Evonik
• HiMedia
• Ingredion
• Kerry Group
• Naturex
• Neogen
• NCIMB
Global Microbial Cultures Market: Product Segment Analysis:
• Starter Cultures
• Adjunct and Aroma Cultures
• Probiotics
• Others
Global Microbial Cultures Market: Application Segment Analysis:
• Bakery and Confectionery
• Dairy
• Fruits and Vegetables
• Beverages
• Others
The Report Covers In- Depth Analysis As Follows:
• Chapter 1 Overview of Microbial Cultures Market
• Chapter 2 Global Market Status and Forecast by Regions
• Chapter 3 Global Market Status and Forecast by Types
• Chapter 4 Global Market Status and Forecast by Downstream Industry
• Chapter 5 Market Driving Factor Analysis of Microbial Cultures Market
• Chapter 6 Microbial Cultures Market Competition Status by Major Manufacturers
• Chapter 7 Microbial Cultures Market Major Manufacturers Introduction and Market Data
• Chapter 8 Upstream and Downstream Market Analysis of Microbial Cultures Market
• Chapter 9 Cost and Gross Margin Analysis of Microbial Cultures Market
• Chapter 10 Marketing Status Analysis of Microbial Cultures Market
• Chapter 11 Report Conclusion
• Chapter 12 Research Methodology and Reference
Read More details – https://www.upmarketresearch.com/reports/microbial-cultures-market-2019
“Microbial Cultures Market Analysis and Forecast 2018- 2025” report helps the clients to take business decisions and to understand strategies of major players in the industry. The report also calls for market- driven results deriving feasibility studies for client needs. UpMarketResearch ensures qualified and verifiable aspects of market data operating in the real- time scenario. The analytical studies are conducted ensuring client needs with a thorough understanding of market capacities in the real- time scenario.
Global Microbial Cultures Market: Key Stakeholders:
• Manufacturers
• Distributors/Traders/Wholesalers
• Subcomponent Manufacturers
• Industry Association
• Downstream Vendors
In this study, the years considered to estimate the market size of Microbial Cultures Market are as follows:
• History Year: 2013-2017
• Base Year: 2017
• Estimated Year: 2018
• Forecast Year 2018 to 2025
Key Reasons to Purchase:
• To gain insightful analyses of the market and have a comprehensive understanding of the “Microbial Cultures Market” and its commercial landscape.
• Learn about the market strategies that are being adopted by your competitors and leading organizations.
• To understand the future outlook and prospects for Microbial Cultures Market analysis and forecast 2018- 2025.
Avail Discount On this Report @ https://www.upmarketresearch.com/home/request_for_discount/77531
Customization of the Report:
Up Market Research provides free customization of reports as per your need. This report can be personalized to meet your requirements. Get in touch with our sales team, who will guarantee you to get a report that suits your necessities.
You can also ask for region wise market research report, as below:
• Microbial Cultures Market – Global Market Status & Trend Report 2013- 2025 Top 20 Countries Data
• Microbial Cultures Market – North America Market Status and Trend Report 2013- 2025
• Microbial Cultures Market – South America Market Status and Trend Report 2013- 2025
• Microbial Cultures Market – Europe Market Status and Trend Report 2013- 2025
• Microbial Cultures Market – EMEA Market Status and Trend Report 2013- 2025
• Microbial Cultures Market – Asia Pacific Market Status and Trend Report 2013- 2025
• Microbial Cultures Market – China Market Status and Trend Report 2013- 2025
• Microbial Cultures Market – India Market Status and Trend Report 2013- 2025
• Microbial Cultures Market – United States Market Status and Trend Report 2013- 2025
About UpMarketResearch:
The UpMarketResearch (www.upmarketresearch.com) is a leading distributor of market research report with more than 800+ global clients. As a market research company, we take pride in equipping our clients with insights and data that holds the power to truly make a difference to their business. Our mission is singular and well- defined – we want to help our clients envisage their business environment so that they are able to make informed, strategic and therefore successful decisions for themselves.
Contact Info:
Name: Alex Mathews
Email: Alex@upmarketresearch.com
Organization: UpMarketResearch
Address: 500 East E Street, Ontario, CA 91764, United States
This release was published on openPR.
Permanent link to this press release:
Copy
Please set a link in the press area of your homepage to this press release on openPR. openPR disclaims liability for any content contained in this release.
You can edit or delete your press release Microbial Cultures Market 2025 Global Analysis By Key Players - Chr. Hansen, DuPont, DSM, Evonik, HiMedia, Ingredion, Kerry Group, Naturex & More, Etc. here
News-ID: 1635755 • Views: …
More Releases from Up Market Research (UMR)
qPCR Reagents Market, Share, Growth, Trends And Forecast To 2025: Up Market Rese …
Up Market Research (UMR), one of the world’s prominent market research firms has released a new report on Global qPCR Reagents Market. The report contains crucial insights on the market which will support the clients to make the right business decisions. This research will help both existing and new aspirants for qPCR Reagents market to figure out and study market needs, market size, and competition. The report talks about the…
Pyrethroid Market Top key Players, Size, Share, Demand, Opportunities And Foreca …
Up Market Research (UMR) has published a latest market research report on Global Pyrethroid Market. The global report is prepared in collaboration with the leading industry experts and dedicated research analyst team to provide an enterprise with in-depth market insights and help them to take crucial business decisions. This report covers current market trends, opportunities, challenges, and detailed competitive analysis of the industry players in the market.
The published report explains…
Pump Jack Market 2025 In-Depth Coverage And Various Important Aspects
Up Market Research (UMR) offers a detailed report on Global Pump Jack Market. The report is a comprehensive research study that provides the scope of Pump Jack market size, industry growth opportunities and challenges, current market trends, potential players, and expected performance of the market in regions for the forecast period from 2020 to 2027. This report highlights key insights on the market focusing on the possible requirements of the…
PTFE Market Expert Guide to Boost the Industry in Global Market Share
Up Market Research (UMR) offers a detailed report on Global PTFE Market. The report is a comprehensive research study that provides the scope of PTFE market size, industry growth opportunities and challenges, current market trends, potential players, and expected performance of the market in regions for the forecast period from 2020 to 2027. This report highlights key insights on the market focusing on the possible requirements of the clients and…
More Releases for Cultures
Global Food And Beverage Protective Cultures Market Size by Application, Type, a …
USA, New Jersey- According to Market Research Intellect, the global Food And Beverage Protective Cultures market in the Internet, Communication and Technology category is projected to witness significant growth from 2025 to 2032. Market dynamics, technological advancements, and evolving consumer demand are expected to drive expansion during this period.
Beginning in 2025 and continuing through 2032, it is anticipated that the market for food and beverage protecting cultures will expand at…
Food Cultures Market Is Booming Worldwide
A Latest intelligence report published by MR Forecast with title "Global Food Cultures Market Outlook to 2032". A detailed study accumulated to offer Latest insights about acute features of the Food Cultures market. This report provides a detailed overview of key factors in the Global Food Cultures Market and factors such as driver, restraint, past and current trends, regulatory scenarios and technology development. Some of the Major Key Players Covered…
Food Cultures Market Report 2024 - Food Cultures Market Size And Demand
"The Business Research Company recently released a comprehensive report on the Global Food Cultures Market Size and Trends Analysis with Forecast 2024-2033. This latest market research report offers a wealth of valuable insights and data, including global market size, regional shares, and competitor market share. Additionally, it covers current trends, future opportunities, and essential data for success in the industry.
Ready to Dive into Something Exciting? Get Your Free Exclusive Sample…
Dairy Cultures Market Analysis by 2020-2025
GLOBAL INFO RESEARCHhas lately published a new report titled, *Global Dairy Cultures Market 2020 by Manufacturers, Regions, Type and Application, Forecast to 2025*. The researchers have offered a broad understanding of the industry with the help of research methodologies such as PESTLE Analysis and Porter's Five Forces.
Click to view the full report TOC, figure and tables: https://www.globalinforesearch.com/Global-Dairy-Cultures_p394963.html
At the start, the report lays emphasis on the key trends and opportunities that…
Meat Cultures Market Analysis By Dupont DSM Chr. Hansen Ambello Bacteria Culture …
Meat Cultures Market Report includes the estimation of the market size of value and volume. Both top-down and bottom-up procedures have been used to estimate and validate the market size of Meat Cultures key plan in the market have been identifying through Second research and their market shares have been calculated through primary and secondary research. This report also studies the top manufacturers, customers, focuses on production, capacity, consumption, value,…
Protective Cultures Market
Increasing demand for natural preservative-free products across the globe is driving the need for protective cultures market. Furthermore, the growing demand for perishable products with extended shelf life worldwide is also projected to influence the protective cultures market significantly. Moreover, increasing concerns for food wastage is also projected to have a robust impact on the protective cultures market. Increasing awareness about green food labels among consumers is also expected to…